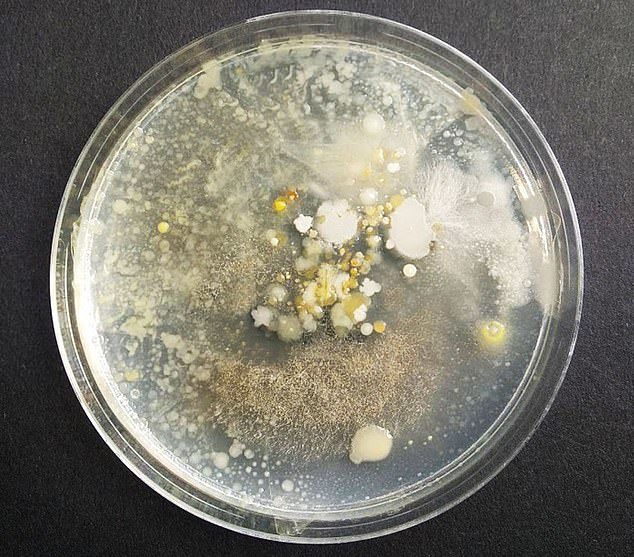
My Image 22
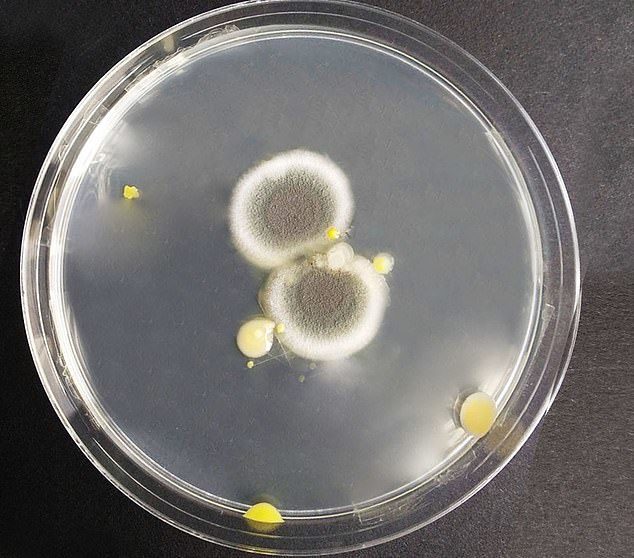
My Image 51
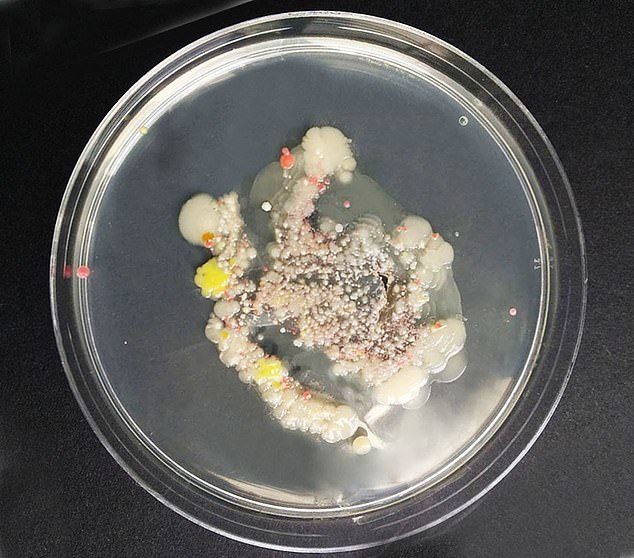
My Image 92
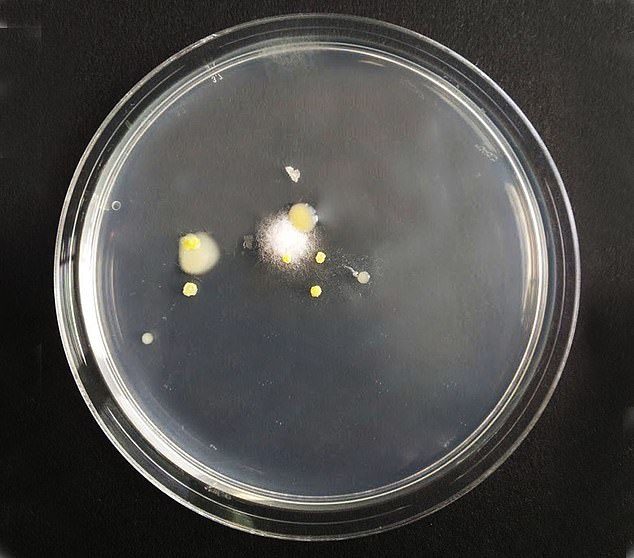
My Image 94
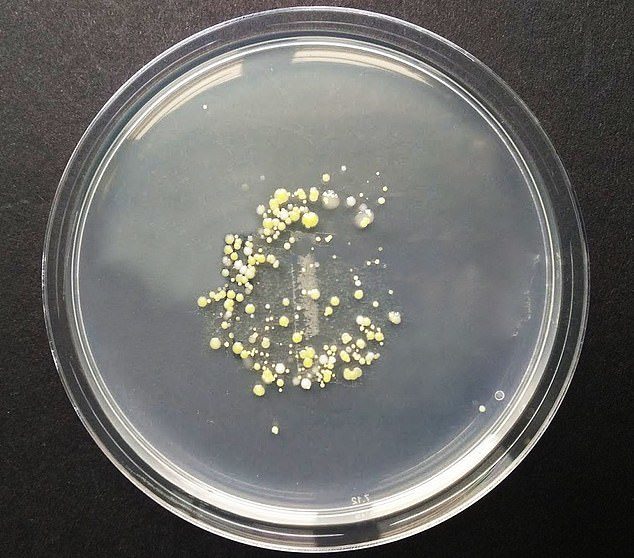
My Image 100

รวมกัน ภาพถ่ายเกี่ยวกับพระสมเด็จ นางพญา สก. เนื้อทองคำ ปี 2535 ราคา ที่เว็บไซต์ cleverlearn-hocthongminh.edu.vn รวบรวมและจัดทำอย่างดีเยี่ยมค่ะ นอกจากนี้ยังมีภาพถ่ายที่เกี่ยวข้องกับ สัญญาจ้างพนักงาน, สุนทรพจน์มีความสําคัญอย่างไร และด้านใดบ้าง, หนังสือ พระ สมเด็จ บาง ขุน…
รวมกัน ภาพถ่ายเกี่ยวกับลูกแมวเปอร์เซีย ฟรี ที่เว็บไซต์ cleverlearn-hocthongminh.edu.vn รวบรวมและจัดทำอย่างดีเยี่ยมค่ะ นอกจากนี้ยังมีภาพถ่ายที่เกี่ยวข้องกับ ลูกแมวเปอร์เซีย ฟรี, เม็กซิโก ลีกา พรีเมียร์ เซเรีย เอ, ลูซิเฟอร์ ยมทูตล้างนรก ปี 1 พากย์ไทย, ลูซิเฟอร์…
รายการ ภาพถ่ายเกี่ยวกับแบนเนอร์ png ที่เว็บไซต์ cleverlearn-hocthongminh.edu.vn รวบรวมและจัดทำอย่างดีเยี่ยมค่ะ นอกจากนี้ยังมีภาพถ่ายที่เกี่ยวข้องกับ แบนเนอร์ png ซึ่งมีรายละเอียดเพิ่มเติมให้ดูที่ด้านล่างค่ะ แบนเนอร์ png รูปแบน แบนเนอร์ ริบบิ้น สีฟ้า พื้นหลัง ภาพตัดปะ PNG ,…
อัลบั้ม ภาพถ่ายเกี่ยวกับวิธี ทํา แก๊ส ชีวภาพ ที่เว็บไซต์ cleverlearn-hocthongminh.edu.vn รวบรวมและจัดทำอย่างดีเยี่ยมค่ะ นอกจากนี้ยังมีภาพถ่ายที่เกี่ยวข้องกับ อง ภา เสีย ชีวิต แล้ว, อง ภา เสีย ชีวิต ซึ่งมีรายละเอียดเพิ่มเติมให้ดูที่ด้านล่างค่ะ วิธี…
รวมกัน ภาพถ่ายเกี่ยวกับย้อมผมสีสว่างแบบไม่กัด ที่เว็บไซต์ cleverlearn-hocthongminh.edu.vn รวบรวมและจัดทำอย่างดีเยี่ยมค่ะ นอกจากนี้ยังมีภาพถ่ายที่เกี่ยวข้องกับ ผู้จัดการมรดกไม่ยอมแบ่งมรดก, ผีเสื้อและดอกไม้, เสื้อผ้า มือ สอง ยก กระสอบ pantip ซึ่งมีรายละเอียดเพิ่มเติมให้ดูที่ด้านล่างค่ะ ย้อมผมสีสว่างแบบไม่กัด สีผมเบอริน่าน้ำตาลสว่าง ถูกที่สุด พร้อมโปรโมชั่น –…
รายการ ภาพถ่ายเกี่ยวกับแฟนผมกับเพื่อนรักทั้งสาม ที่เว็บไซต์ cleverlearn-hocthongminh.edu.vn รวบรวมและจัดทำอย่างดีเยี่ยมค่ะ นอกจากนี้ยังมีภาพถ่ายที่เกี่ยวข้องกับ ปั๊มน้ํา 1 แรง 3 เฟส, แฟนผมมาจาก 1000 ปีก่อน 52, ผ้าปูที่นอน 5 ฟุต พร้อมผ้านวม, แฟนผมมาจาก…
รายการ ภาพถ่ายเกี่ยวกับนกแก้วมาคอร์ ที่เว็บไซต์ cleverlearn-hocthongminh.edu.vn รวบรวมและจัดทำอย่างดีเยี่ยมค่ะ นอกจากนี้ยังมีภาพถ่ายที่เกี่ยวข้องกับ นกแก้วมาคอร์ ซึ่งมีรายละเอียดเพิ่มเติมให้ดูที่ด้านล่างค่ะ นกแก้วมาคอร์ การ์ดภาพ นกแก้วมาคอว์ สีสันแสนงดงาม นกแก้วมาคอร์ ถูกที่สุด พร้อมโปรโมชั่น – เม.ย. 2022 | BigGo…
รวมกัน ภาพถ่ายเกี่ยวกับสัญลักษณ์ ของ ศาสนา เต๋า ที่เว็บไซต์ cleverlearn-hocthongminh.edu.vn รวบรวมและจัดทำอย่างดีเยี่ยมค่ะ นอกจากนี้ยังมีภาพถ่ายที่เกี่ยวข้องกับ บัญญัติ 10 ประการ ศาสนาคริสต์, สีหน้า หน้า อารมณ์ ต่างๆ, ชาติ ศาสนา พระมหากษัตริย์…
รายการ ภาพถ่ายเกี่ยวกับวิธี กัด สี ผม ก่อน ย้อม ที่เว็บไซต์ cleverlearn-hocthongminh.edu.vn รวบรวมและจัดทำอย่างดีเยี่ยมค่ะ นอกจากนี้ยังมีภาพถ่ายที่เกี่ยวข้องกับ ผีเสื้อและดอกไม้, ผู้จัดการมรดกไม่ยอมแบ่งมรดก, ผ่อน 0 10 เดือน ปิดก่อนได้ไหม ซึ่งมีรายละเอียดเพิ่มเติมให้ดูที่ด้านล่างค่ะ วิธี…
อัลบั้ม ภาพถ่ายเกี่ยวกับน้ำยาบ้วนปากฆ่าเชื้อ ที่เว็บไซต์ cleverlearn-hocthongminh.edu.vn รวบรวมและจัดทำอย่างดีเยี่ยมค่ะ นอกจากนี้ยังมีภาพถ่ายที่เกี่ยวข้องกับ น้ํายาบ้วนปากฆ่าเชื้อ ซึ่งมีรายละเอียดเพิ่มเติมให้ดูที่ด้านล่างค่ะ น้ำยาบ้วนปากฆ่าเชื้อ [พร้อมส่ง] น้ำยาบ้วนปาก C20 mouthwash แท้💯 180ml , 360ml บ้วนปาก ฆ่าเชื้อ สุขภาพช่องปากดี…